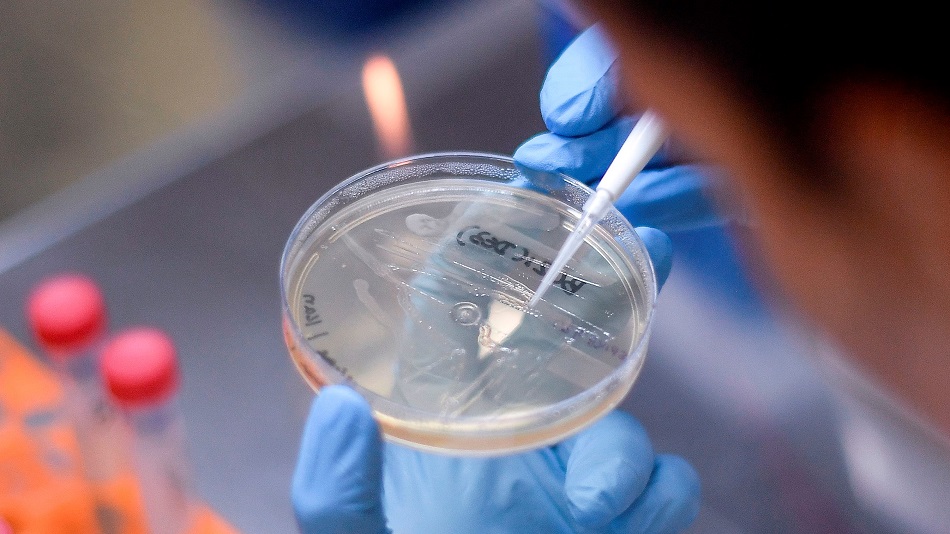

Covid Berlin Updates


Coronavirus Global Updates College Campus Cases Climb Nyc Museums Reopen Virus Update
www.bloombergquint.com

Covid 19 Innovative Tools And Solutions To Optimise Public Transport Services During A Pandemic It Trans
www.it-trans.org
































/posttv-thumbnails-prod.s3.amazonaws.com/08-01-2020/t_91db18580637402597dfd708ffe77645_name_20200731_protests_berlin_getty.jpg)